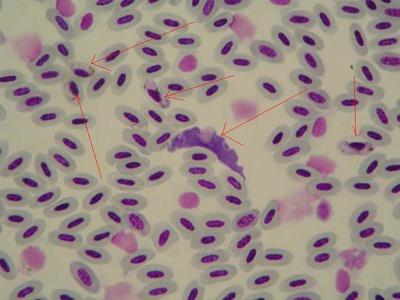
trypanosoma en sangre de ave.JPG
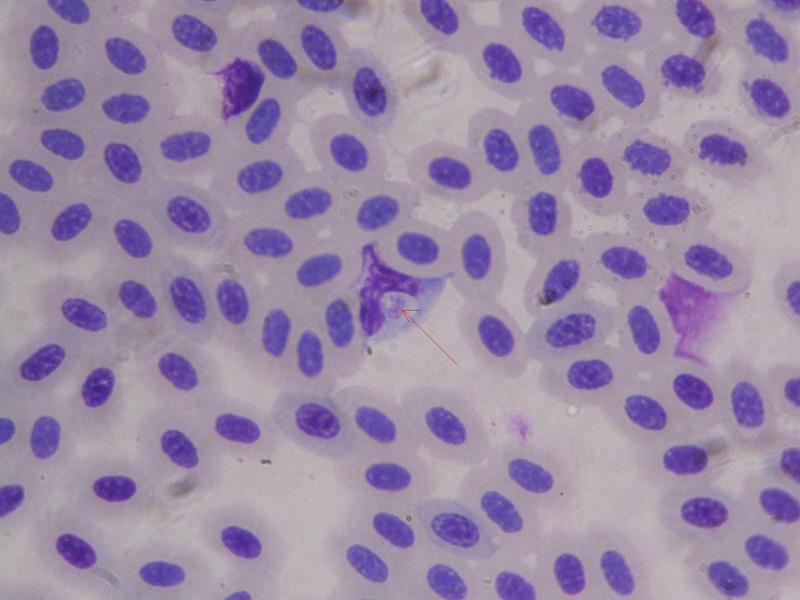
Lankesterella sp.jpg

Página 70 de 80
Re: Fotos de análisis Coprológicos de nuestas aves.
Publicado: Mié Mar 19, 2014 2:27 pm
por NOVATO08
salobreña escribió:Hola bensliman
Bueno en realidad cada cual lo hace como puede, yo por ejemplo utilizo una camara digital acoplada al micro, pero estuve mucho tiempo haciendolo con camara exterior como lo haces tu, y las fotos quedaban bastante legibles……intentare daros una pequeña explicación a los que usais micros binoculares y a los que fotografiais exteriormente con camara o movil, ya que a veces y por lo menos al amigo mlopez le sale en algunas fotos el propio micro e incluso parte de la mesa donde lo tiene instalado.
Primero vamos a intentar graduar los oculares a la vista del usuario…….esto son cosas de manual pero es posible que alguno de vosotros no lo haya leido nunca…….los micros binoculares como su nombre indica tienen dos oculares……por norma uno de estos oculares es fijo, y el otro es graduable en dioptrias, e includo algunas en algunas marcas son graduables los dos, esto es asi porque no hay dos personas que vean igual cada una con sus ojos, y tambien porque ninguna persona ve exactamente igual con un ojo que con el otro, pues entre un ojo y otro hay diferencias como las hay entre el brazo derecho y el izquierdo, o el oido de un lado y otro, o entre un pie y el otro.
Primer paso…… los oculares tambien son graduables en distancia, ya que cada individuo tiene una medida craneal y la distancia entre ojos no tiene porque coincdir entre uno y otro individuo……bien pues vamos a ponerlos a nuestra medida ayudandonos con la dos manos…….situamos una muestra en el porta a observar con el objetivo de 40X y enfocamos la muestra como de costumbre primero con el macrometrico y luego con el micrometrico, una vez enfocada, graduamos con ambas manos los oculares en distancia los acrecamos uno a otro o los separamos, hasta que veamos un circulo solo, evitando aquella vision cinematografica de cuando algunos de los actores de la pelicula mira con unos prismaticos que se refleja en pantalla con dos halos de vision…….esta vision es incorrecta, hemos de graduar nuestros oculares hasta que podamos ver solo un halo y posteriormente comprobamos que no estamos errando, cerrando un ojo y después el otro, comprobando asi que cada ojo esta encima de su ocular.
Segundo paso graduación de dioptrias…… esta graduación se hace con un mando circular que hay en la base de los portaoculares y que funciona a rosca bastante sensible y facil de manejar…….con la misma muestra y fijandonos en un objeto claro de ella, damos paso a la graduación de las dioptrias de cada cual…...en los micros que los dos oculares garduables, hacemos un enfoque maximo con el micrometrico del objeto en el que nos hayamos fijado…… y cerrando un ojo activamos el mando rosca hasta alcanzar la maxima resolucion en un ojo y luego hacemos lo mismo con el otro.
En lo micros de un solo ocular graduable, comenzaremos la graduación por el ocular fijo y cerrando el ojo contrario a este ocular y enfocando con el micrometrico……una vez hayamos graduado este ojo cerramos el ojo graduado y hacemos lo mismo con el otro ojo pero esta vez SIN TOCAR EL ENFOQUE PARA NADA solo graduamos con el mando rosca que hay en la base del porta ocular, hasta que veamos la maxima claridad sin abrir el ojo contrario.
Esto parecera una tonteria pero si no lo hacemos bien, a la hora de hacer una foto exterior puede que se pierda mucha resolucion……y ahora pasamos al ultimo paso que el de cómo hacer la foto desde el exterior…..estos ajustes solo se hacen una sola vez, si el micro solo lo usa una persona, aunque no esta de mas hacerlo de tarde en terde.
A la hora de hacer una foto exteriomente se necesita un poco de calma un poco de maña y un poco de pulso……..lo primero que hemos de hacer es hacerle a la camara o el movil un poco de zoom ((entre 4 y 5)) todas las camaras digitales incluyendo las de los telefonos moviles tienen la opcion de operar con el zoom, solo es una cuestion de manejo……si no hacemos zoom, solo veremos un circulo lejano en la foto muy difícil de leer.
Si ya tenemos en objeto que queremos fotografiar bien enfocado en el micro, ahora hay que enfocarlo para la camara, pues aunque este enfocado para nuestra vista, no quiere decir que este enfocado para la camara pues el ojo de la camara no tiene porque coincidir con el nuestro o si……..como digo lo primero es hacer un zoom de 4 0 5 unidades, y luego mirando a traves de la pantalla de la camara, la sujetamos con una mano y con la otra intentamos enfocar con el micrometrico del micro a traves de la pantalla de la camara, hasta que alcanzamos la maxima resolucion, y cuando asi lo creamos se hace el disparo y ahora si sujetando la camara con las dos manos y procurando que no se mueva…… y eso es todo …….saludos
PD: benslimam si tu micro es de un solo ocular, almenos aplica el ultimo parrafo.
Disculpar x volver a subir este post, acabo de leerlo y me parece superinteresante para los novatos como yo.
Don Manuel muchas gracias vaya currada, muy bien explicado, Ud siempre en su linea.
tengo que empezar a leer mucho este post ya que me an informado que an encontrado mi pakete k habia perdido los reyes
Saludos cordiales
Re: Fotos de análisis Coprológicos de nuestas aves.
Publicado: Vie Mar 21, 2014 9:45 am
por JUA
unas fotillos de una jilguera que por lo visto tiene megas la he puesto en tratamiento con fungi,enrro y protector haber si la he cogido a tiempo un saludo compis
Re: Fotos de análisis Coprológicos de nuestas aves.
Publicado: Vie Mar 21, 2014 5:42 pm
por salobreña
Hola buenas
Jua, preciosas fotos, espero que lo de la canaria se solucione.
Os dejo unas fotos de sangre de aves recogidas de internet.
En esta primera foto vemos sangre de carbonero comun, afectado por malaria aviar, la flecha roja muestra un eritrocito infectado por una de las etapas del parasito.

- Malaria aviar.jpg (17.1 KiB) Visto 6113 veces
En esta segunda foto, es sangre de curruca capirotada, infestada por una de las especies de tripanosoma, y el parasito esta presente en varios estadíos.
- trypanosoma en sangre de ave.JPG (21.87 KiB) Visto 6113 veces
Y por ultimo otro conocido, un monocito de curruca capirotada, infectado por el parasito de atoxoplasma.
- Lankesterella sp.jpg (47 KiB) Visto 6113 veces
Saludos
Re: Fotos de análisis Coprológicos de nuestas aves.
Publicado: Sab Mar 22, 2014 1:31 pm
por JUA
Muy interesante MANUEL sobre todo lo de atoxoplasmosis esta enfermedad se da con cierta frecuencia ,gracia por las fotos
Re: Fotos de análisis Coprológicos de nuestas aves.
Publicado: Sab Mar 22, 2014 7:40 pm
por Pedro J
Hola a todos.
Bueno veo que el pots va muy bien y que se esta poniendo interesante,jo de momento no puedo intervenir colocando fotos ni tan solo opinar por falta de tiempo,pero a la que encuentre un hueco apareceré como pueda,jejeje.
Un saludo a todos y espero estar entre vosotros pronto.
Re: Fotos de análisis Coprológicos de nuestas aves.
Publicado: Sab Mar 22, 2014 8:48 pm
por JUA
Pedro J escribió:Hola a todos.
Bueno veo que el pots va muy bien y que se esta poniendo interesante,jo de momento no puedo intervenir colocando fotos ni tan solo opinar por falta de tiempo,pero a la que encuentre un hueco apareceré como pueda,jejeje.
Un saludo a todos y espero estar entre vosotros pronto.
Hombre amigo PEDRO que alegría me ha dado ver tu post sabemos tu falta de tiempo lo primero es lo primero
pero la verdad es que te se hecha de menos, un saludo amigo
Re: Fotos de análisis Coprológicos de nuestas aves.
Publicado: Sab Mar 22, 2014 10:24 pm
por salobreña
Pedro J escribió:Hola a todos.
Bueno veo que el pots va muy bien y que se esta poniendo interesante,jo de momento no puedo intervenir colocando fotos ni tan solo opinar por falta de tiempo,pero a la que encuentre un hueco apareceré como pueda,jejeje.
Un saludo a todos y espero estar entre vosotros pronto.
Hola Pedro
Alegria nos da saberte por aqui, espero que pronto te desenlies, y podamos verte por aqui mas a menudo, un abrazo y hata que lo veas oportuno, lo primero es lo primero......un abrazo.
Re: Fotos de análisis Coprológicos de nuestas aves.
Publicado: Dom Mar 23, 2014 12:41 pm
por JUA
Hola compis ,unas fotillos de un rato de trapicheo ,nada nuevo.
Re: Fotos de análisis Coprológicos de nuestas aves.
Publicado: Dom Mar 23, 2014 7:44 pm
por salobreña
Hola Jua
La segunda foto es una megabacteria deteriorada, probablemente muerta por algun antifungico........los antifungicos como la anfotericina y la nistatina y otros atacan y deterioran la menbrana exterior de los hongos y levaduras como estas, perdiendo asi sus fluidos y muriendo, es por eso que la capa exterior no se ha teñido, y si sus nucleos que aguantan mas la descomposicion......tambien es posible que se deba a una muerte natural de la megabacteria, pero cabe la posibilidad que el pajaro que la arrojo se este tratando con antifungicos.
La tercera foto no reconozco nada, las manchas grandes al teñir de rosa debe de ser vegetal, por lo demas no distingo nada......las dos ultimas muy guapas, como siempre.......saludos
Re: Fotos de análisis Coprológicos de nuestas aves.
Publicado: Dom Mar 23, 2014 9:03 pm
por mlopez
Bueno a ver si lo consigo jaja que envidia sana un saludoooo
[ Post made via Windows Smartphone ] 
Re: Fotos de análisis Coprológicos de nuestas aves.
Publicado: Jue Mar 27, 2014 9:08 pm
por joustia
Aprovecho la tesitura para hacer dos cuestiones sobre las megas, la primera...aunque sabemos q la anfo b es lo mas efectivo contra las megas la nistatina ( llamese Mycostatin) las mata también? Y otra pregunta es si es normal que en un examen coprológico pueda salir alguna megabacteria,es decir,si es típico que los pájaros tengan alguna aunque ésta no le afecte?
Re: Fotos de análisis Coprológicos de nuestas aves.
Publicado: Vie Mar 28, 2014 9:35 pm
por salobreña
joustia escribió:Aprovecho la tesitura para hacer dos cuestiones sobre las megas, la primera...aunque sabemos q la anfo b es lo mas efectivo contra las megas la nistatina ( llamese Mycostatin) las mata también? Y otra pregunta es si es normal que en un examen coprológico pueda salir alguna megabacteria,es decir,si es típico que los pájaros tengan alguna aunque ésta no le afecte?
Hola
La nistatina, el fluconazol, el itraconazol, y otros tambien combaten las megas, pero no con la eficaia de la anfotericina-b, de todas formas como en todos los patogenos hay cepas de megabacterias que presentan severas resistencia incluso a la anfotericina.
Despues de muchas muestras y experiencias he visto muchos pajaros con megas que no sufren ningun deterioro por ello, tambien he visto pajaros sufriendo por las megas, pero lo que mas he visto son pajaros con megas y organos dañados y a veces irecuperables por culpa de los tratamientos.....saludos
Re: Fotos de análisis Coprológicos de nuestas aves.
Publicado: Vie Mar 28, 2014 11:10 pm
por joustia
Pero siempre será menos dañino para el pajaro un Mycostatin que un Funguizone y las dos las pueden quitar.
Re: Fotos de análisis Coprológicos de nuestas aves.
Publicado: Lun Abr 14, 2014 9:17 pm
por salobreña
Hola Buenas
Os dejo una foto curiosa......a veces enfermedades como la coccidiosis, infeciones bacterianas, u otros parasitos como nematodos, pueden producir hemorragias detectadas en las heces.....estas hemorragias pueden ir de insignificantes a severas, en este caso de la foto se trata de un pajaro con coccidiosis, y en sus heces nada hacia sospechar que pudiera haber restos de samgre, pero al observarlas al micro se ven claramente las celulas sanguineas mas comunes en la sengre los eritrocitos((globulos rojos)) que se ven en el fondo de la muestra.......solo recalcar que no eran visibles en toda la muestra solo estaban en un sector......saludos

- TS_04_01_17_44_33.jpg (136.97 KiB) Visto 5850 veces
Re: Fotos de análisis Coprológicos de nuestas aves.
Publicado: Lun Abr 14, 2014 9:46 pm
por coroneldelinares2
Es verda que se aprecian manuel... Esta jodio ese pajaro o qud
[ Post made via Android ] 